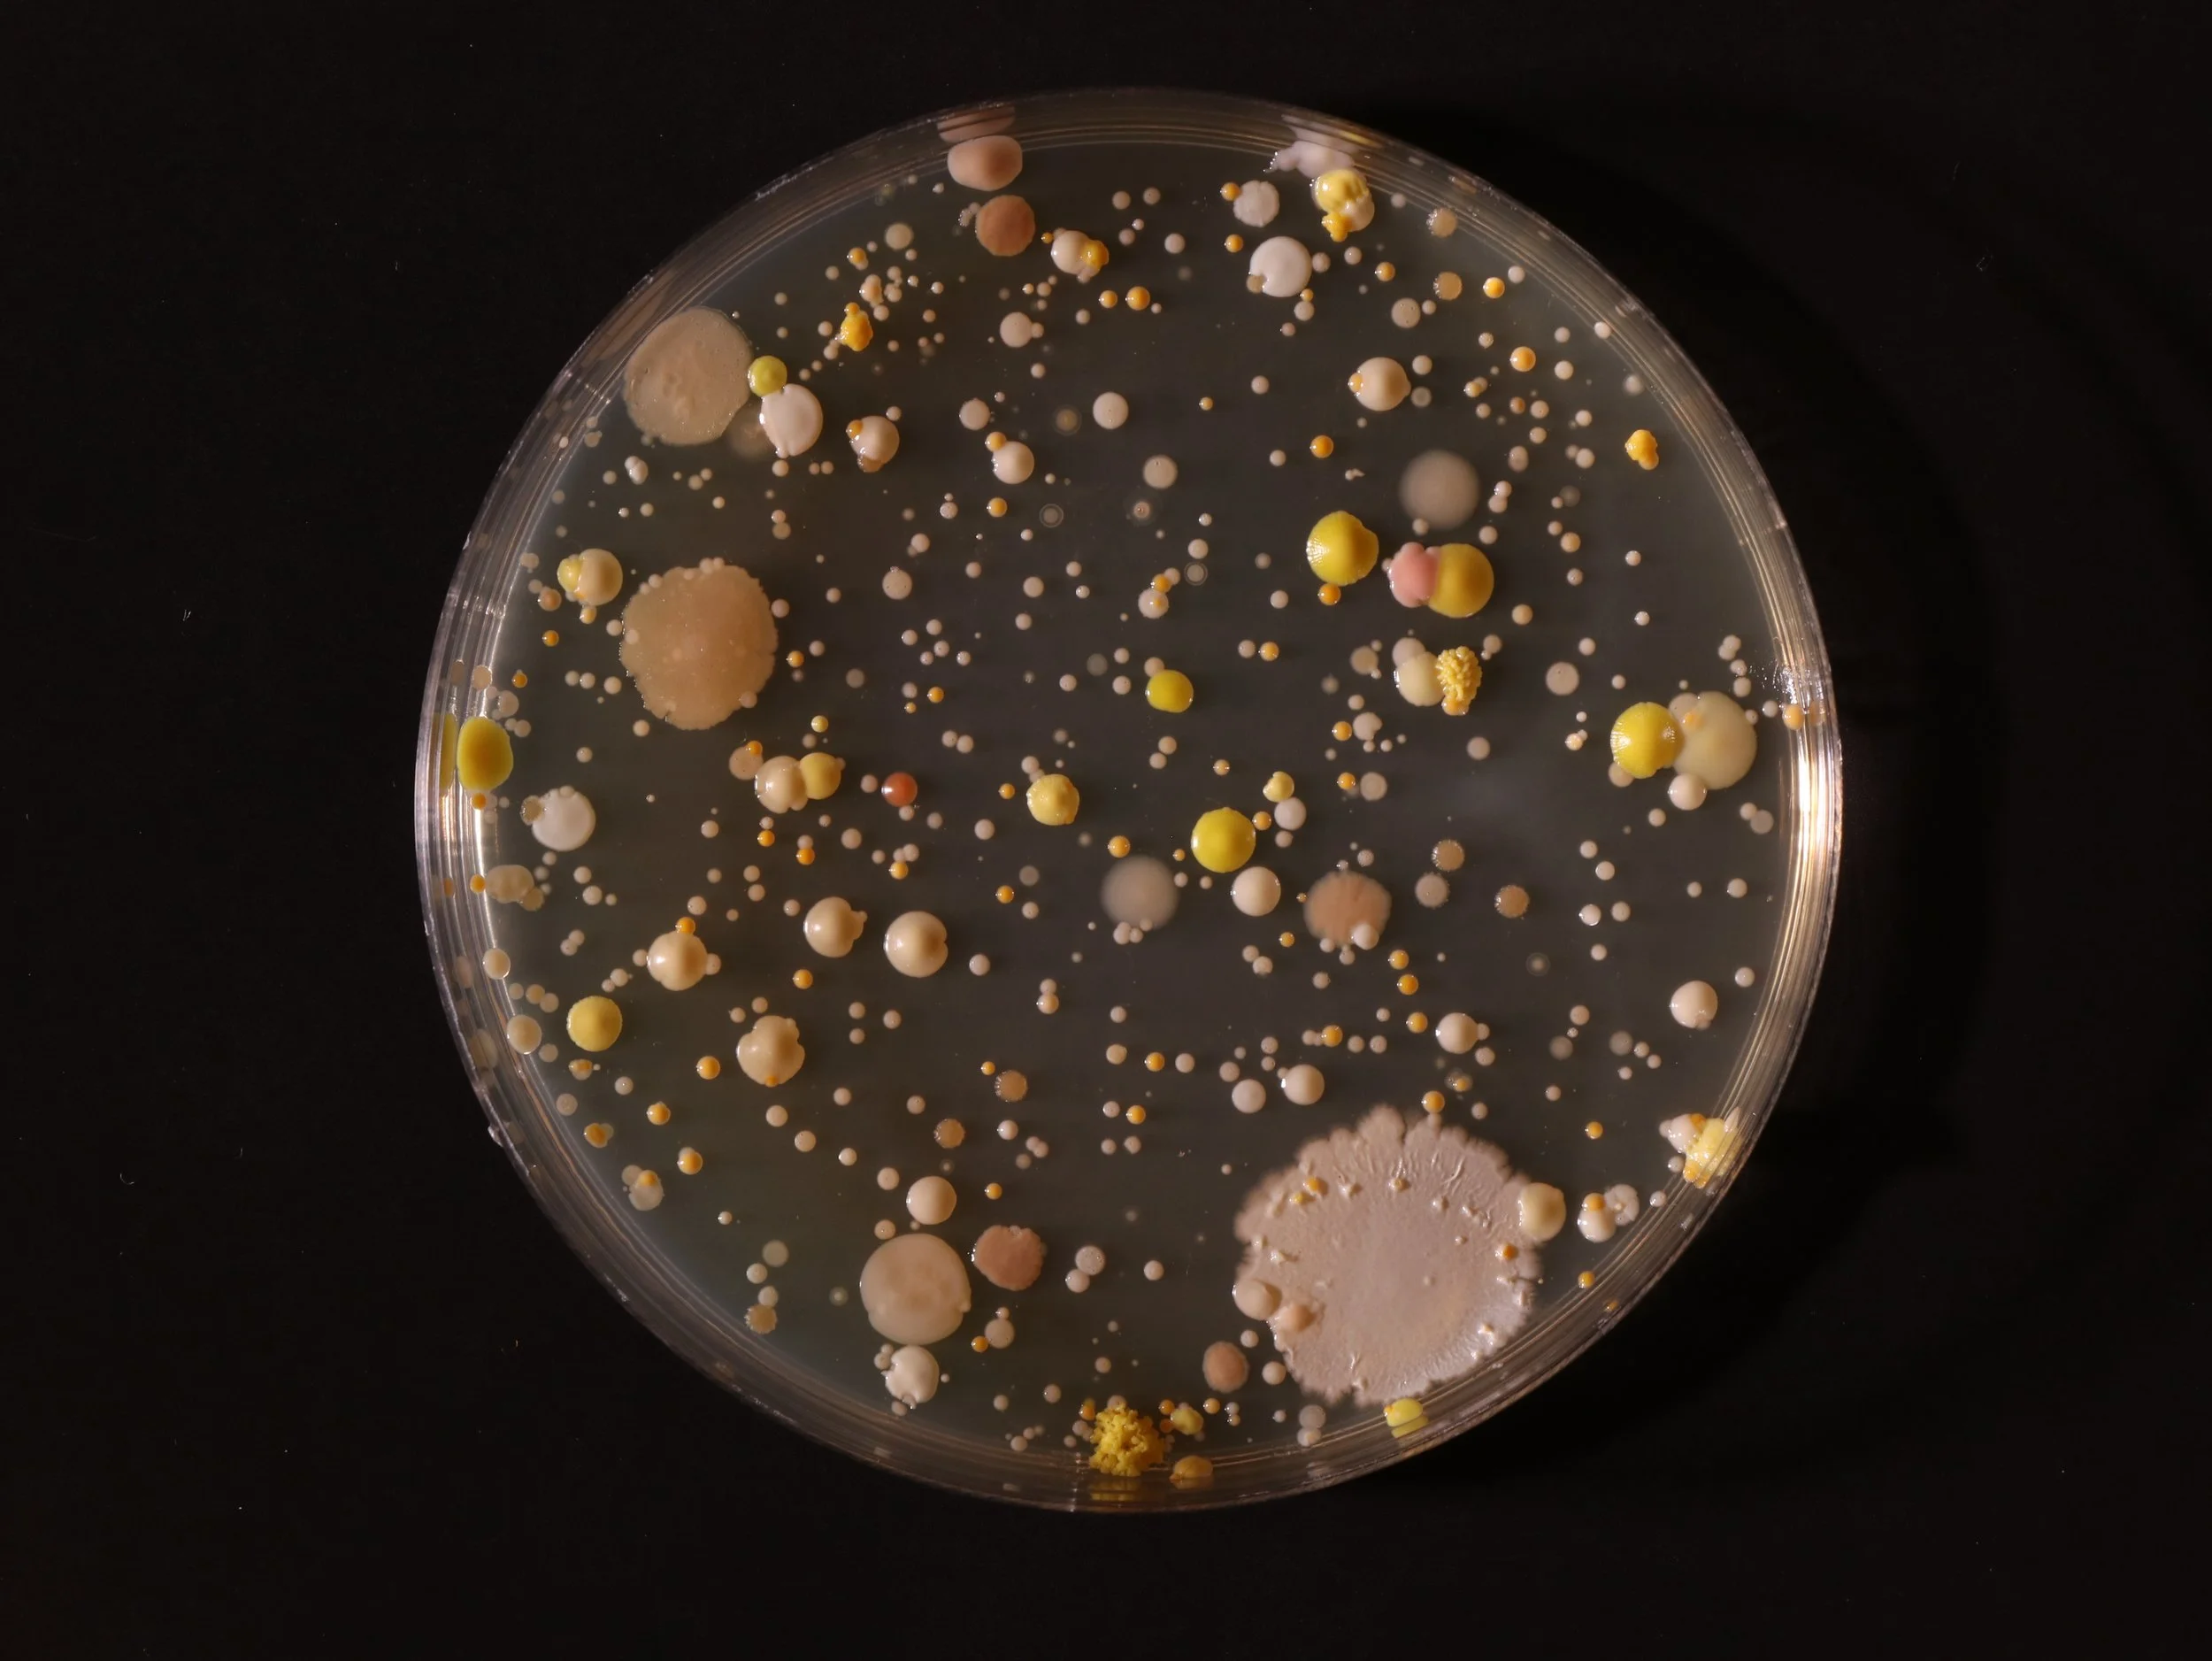

In this bacteria painting series, Ajaya uses different kinds of bacteria present in our surroundings by taking swabs from different surfaces and collecting the samples in different Petri dishes. She then allows the bacteria to grow naturally and after the desired growth has taken place, she adds different pigments and dyes to the Petri dishes and observes how the bacteria colonies react to the dyes and pigments.
The Galaxy
100 mm (diameter) x 15 mm
Medium: agar, bacteria, acrylic paint
2023
Hands
100 mm (diameter) x 15 mm
Medium: agar, bacteria, blue drawing ink
2023
100 mm (diameter) x 15 mm
Medium: agar, bacteria, linseed oil, oil paint
2023
Studio
Fuzz
100 mm (diameter) x 15 mm
Medium: agar, bacteria, white fabric dye
2023